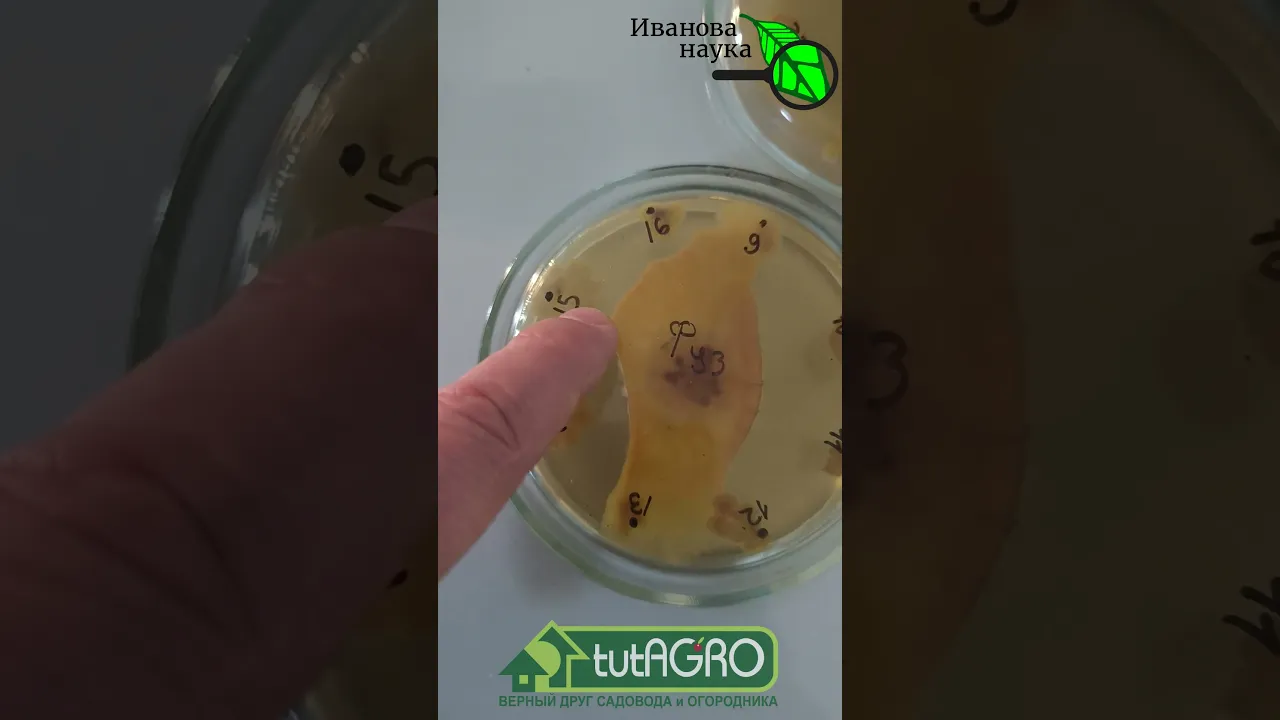

Усе відэа з катэгорыі Палітыка

24:51

03:53

21:05
ДРОЗДЫ- 13 гадзін таму
- 676 праглядаў

02:58

19:16

16:36
02:15

08:05

16:21

59:24

09:45

01:00:18
MotoGO- 14 гадзін таму
- 44 274 прагляды

39:33

04:49:18
UGLUK- 14 гадзін таму
- 484 прагляды

11:30

56:19

09:35

20:09

11:34

59:34